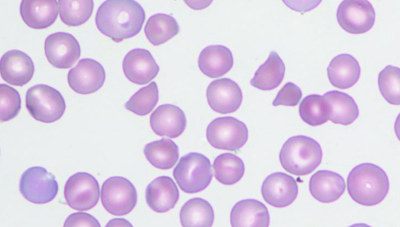
#

67歳の男性。意識障害のため救急車で搬入された。玄関先で倒れているところを妻が発見し、救急車を要請した。4日前にろれつの回らない状態が出現したが翌日には軽快していた。2日前の夕方から38℃台の発熱があった。昨日には再びろれつの回らない状態が出現した。脳梗塞の既往はない。
意識レベルはGCS 11(E3V3M5)。身長 170 cm、体重 68 kg。体温 38.2 ℃。心拍数 88/分、整。血圧 112/78 mmHg。眼瞼結膜は貧血様、眼球結膜に黄染を認める。四肢に紫斑を認める。
血液所見:赤血球214万、Hb 6.5 g/dL、Ht 20%、白血球 7,400、血小板 0.4万。血液生化学所見:総蛋白 7.5 g/dL、アルブミン 3.7 g/dL、総ビリルビン 3.9 mg/dL、直接ビリルビン 0.5 mg/dL、AST 59 U/L、ALT 29 U/L、LD 2,350 U/L(基準 120〜245)、ALP 216 U/L(基準 115〜359)、尿素窒素 40 mg/dL、クレアチニン 2.8 mg/dL、尿酸 19.2 mg/dL、Na 138 mEq/L、K 4.1 mEq/L、Cl 101 mEq/L。頭部MRIでは急性期の微細な多発性脳梗塞を指摘された。末梢血塗抹May-Giemsa染色標本を別に示す。
この患者の診断を確定するために最も重要な検査項目はどれか。
a. FDP
b. PT-INR
c. 出血時間
d. ハプトグロビン
e. ADAMTS-13活性